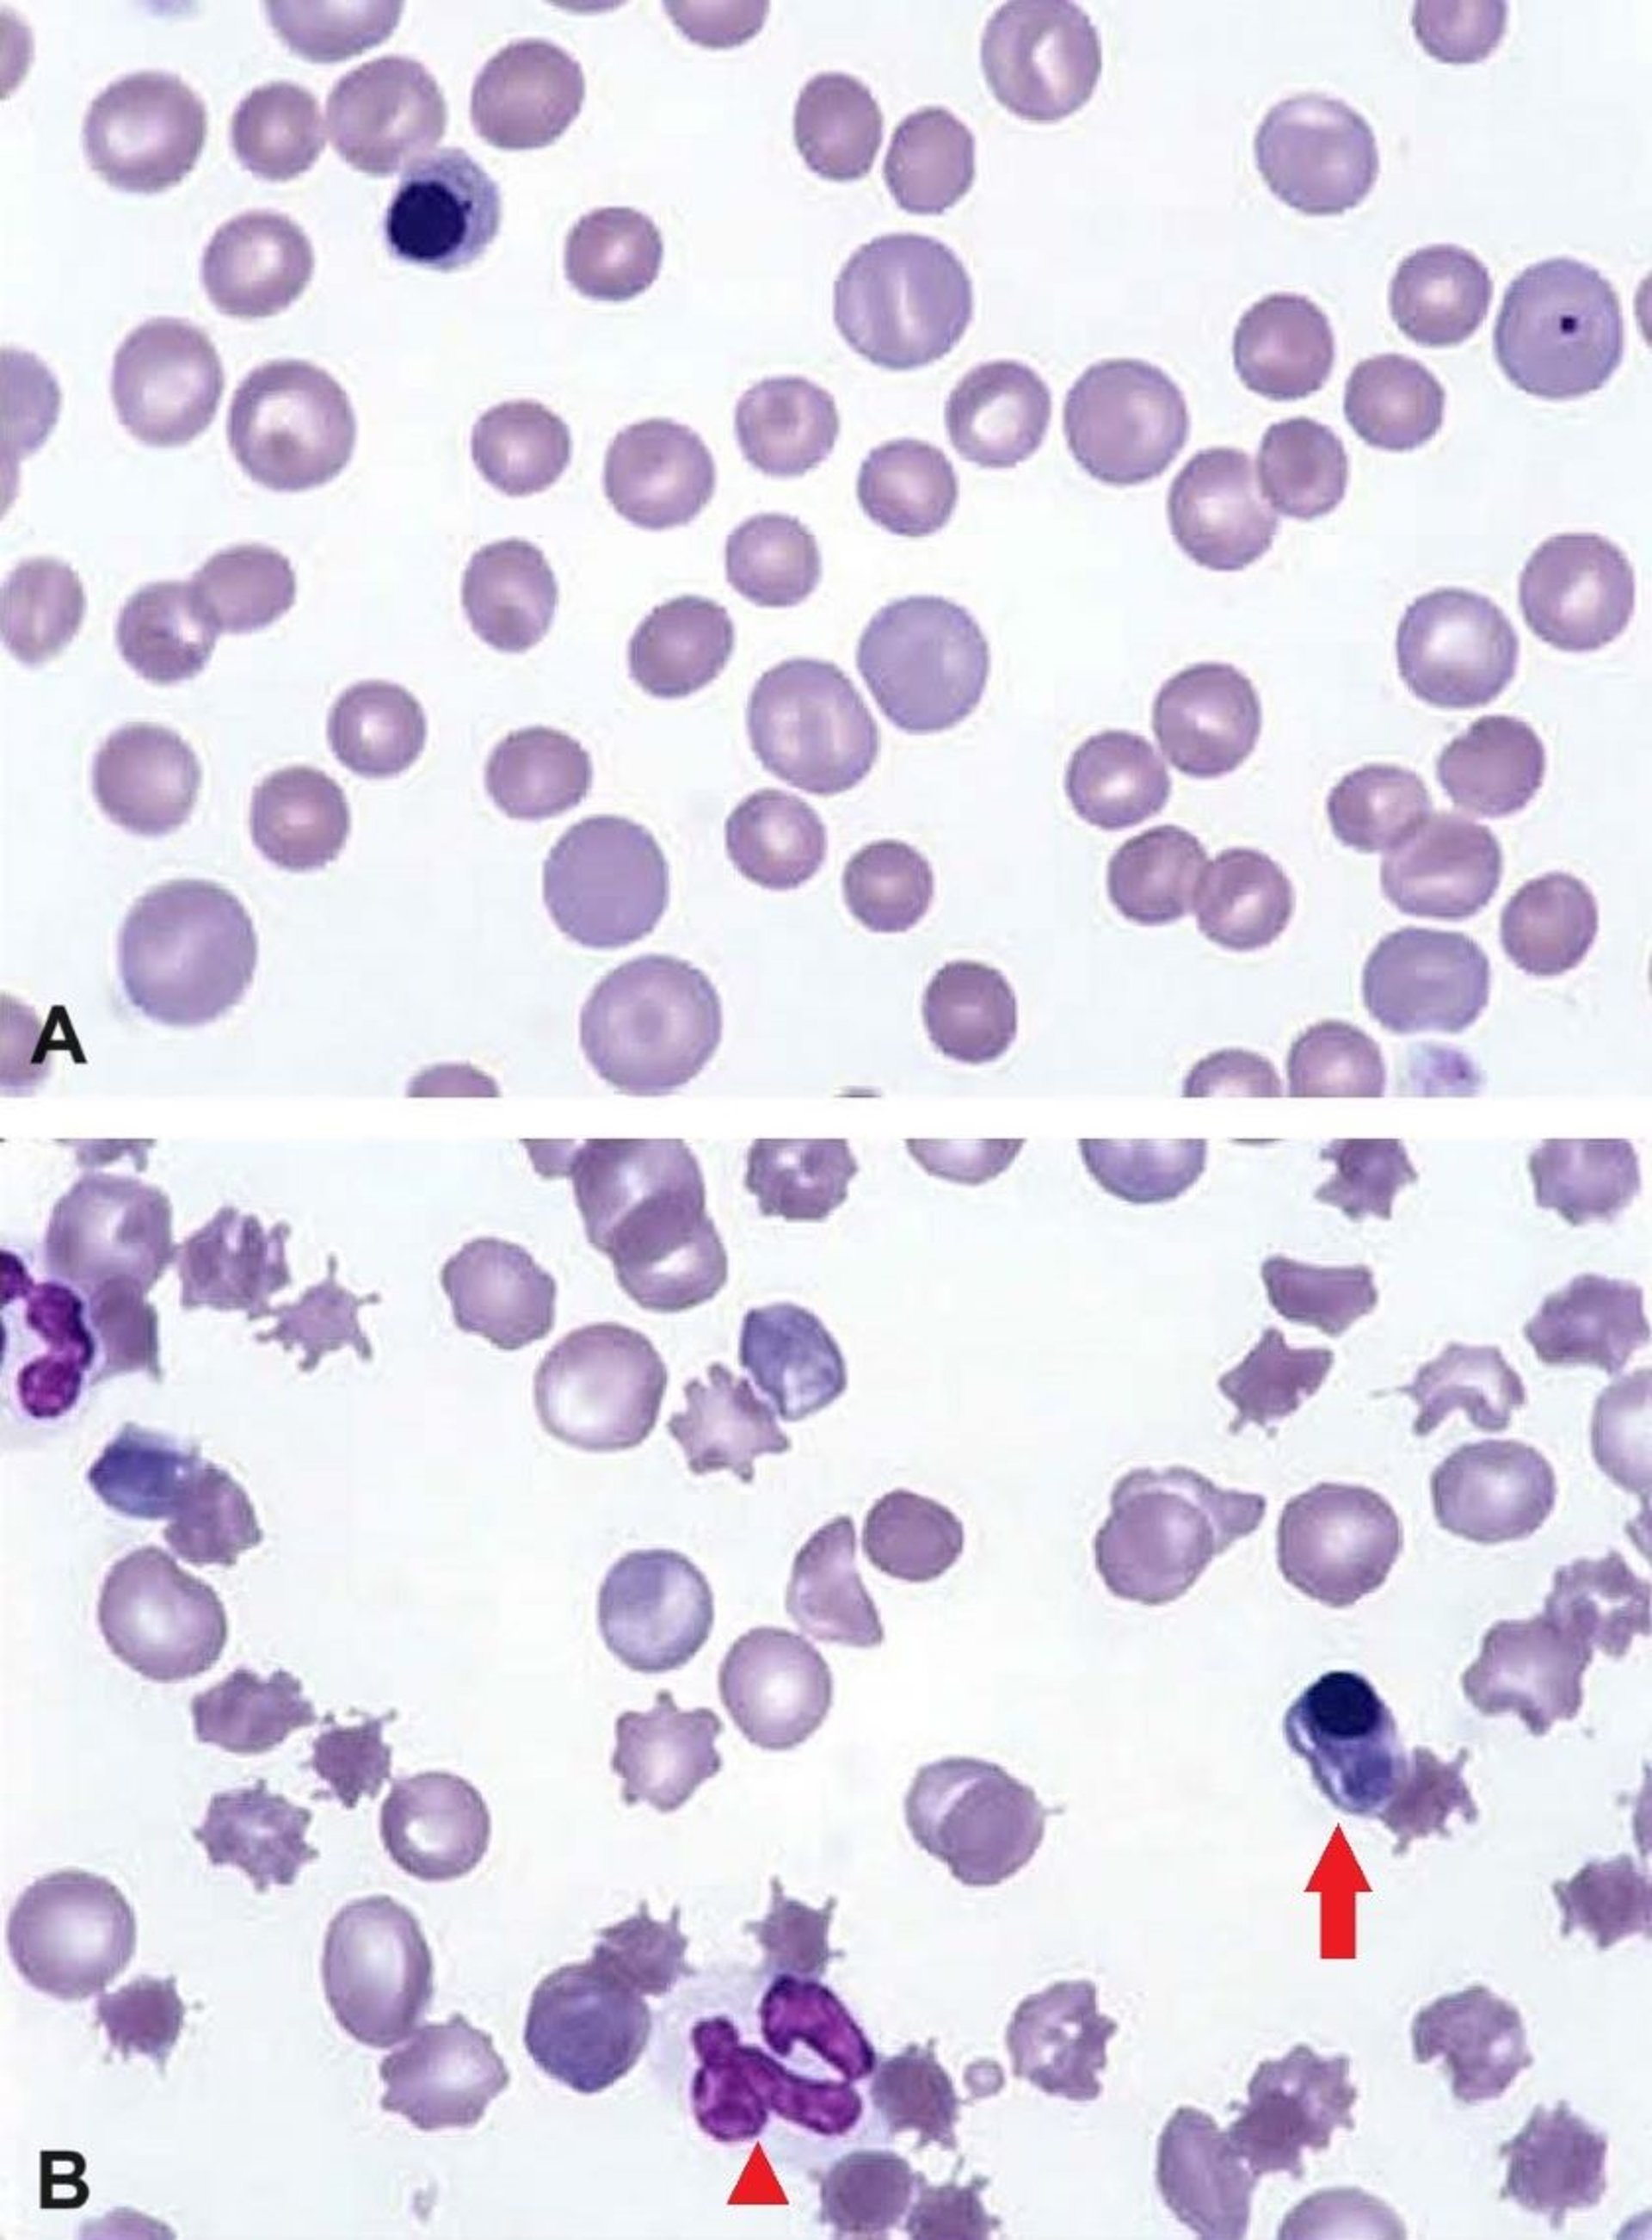
Regenerative anemia, blood smears, dog

Regenerative anemia, blood smears, dog
Photomicrographs showing clinicopathological evidence of regenerative anemia in a dog with a marked regenerative response (A) and a dog with hemangiosarcoma (B). A. Note the frequent large polychromatophilic erythrocytes (reticulocytes) and increased anisocytosis. A nucleated erythrocyte (metarubricyte) is present at upper left; a basophilic, spherical Howell-Jolly body is present in a polychromatophilic cell at upper right. Wright-Giemsa stain; original magnification 1,000X. B. Note the increased polychromasia and acanthocytosis. Acanthocytes (RBCs with a bluntly spiculated membrane with irregular interspacing) commonly accompany regenerative anemia in dogs with hemangiosarcoma. A neutrophil (arrowhead) and a nucleated erythrocyte (metarubricyte; arrow) are also present. Wright-Giemsa stain; original magnification 1,000X).
Courtesy of Dr. John W. Harvey.